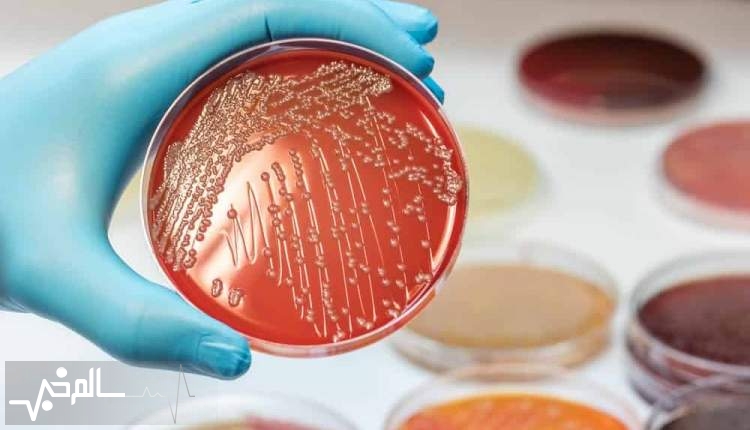

هشدار آمریکا در مورد شیوع باکتری اشریشیا کلی
تاریخ انتشار :
شنبه ۲۸ بهمن ۱۴۰۲ ساعت ۱۶:۱۲
کد مطلب : ۱۶۳۳۲
سالم خبر: مرکز کنترل و پیشگیری از بیماریهای ایالات متحده (CDC) روز گذشته (جمعه) در مورد شیوع باکتری اشریشیا کلی (E. coli) مرتبط با پنیر تهیه شده از شیر غیرپاستوریزه (خام) هشدار داد.
به گزارش سالم خبر، تاکنون ۱۰ نفر مبتلا به اشریشیا کلی از چهار ایالت ایالات متحده گزارش شده است.
همچنین به گفته مرکز کنترل و پیشگیری از بیماری های ایالات متحده، چهار نفر در بیمارستان بستری شدهاند و یک نفر در پی آلوده شدن به این باکتری به سندرم «همولیتیک اورمیک» مبتلا شده است که یک بیماری جدی است که میتواند باعث نارسایی کلیه شود.
اشریشیا کلی یک گروه بزرگ و متنوع از باکتری ها است. اگرچه بیشتر سویه های اشریشیا کلی بی ضرر هستند، اما سایر گونه ها می توانند افراد را بیمار کنند.
به گزارش شینهوا، بر اساس گزارش مرکز کنترل و پیشگیری از بیماری های ایالات متحده، برخی از انواع اشریشیا کلی می توانند باعث اسهال شوند در حالی که برخی دیگر باعث عفونت دستگاه ادراری، بیماری تنفسی و ذات الریه و سایر بیماری ها می شوند.
به گزارش سالم خبر، تاکنون ۱۰ نفر مبتلا به اشریشیا کلی از چهار ایالت ایالات متحده گزارش شده است.
همچنین به گفته مرکز کنترل و پیشگیری از بیماری های ایالات متحده، چهار نفر در بیمارستان بستری شدهاند و یک نفر در پی آلوده شدن به این باکتری به سندرم «همولیتیک اورمیک» مبتلا شده است که یک بیماری جدی است که میتواند باعث نارسایی کلیه شود.
اشریشیا کلی یک گروه بزرگ و متنوع از باکتری ها است. اگرچه بیشتر سویه های اشریشیا کلی بی ضرر هستند، اما سایر گونه ها می توانند افراد را بیمار کنند.
به گزارش شینهوا، بر اساس گزارش مرکز کنترل و پیشگیری از بیماری های ایالات متحده، برخی از انواع اشریشیا کلی می توانند باعث اسهال شوند در حالی که برخی دیگر باعث عفونت دستگاه ادراری، بیماری تنفسی و ذات الریه و سایر بیماری ها می شوند.